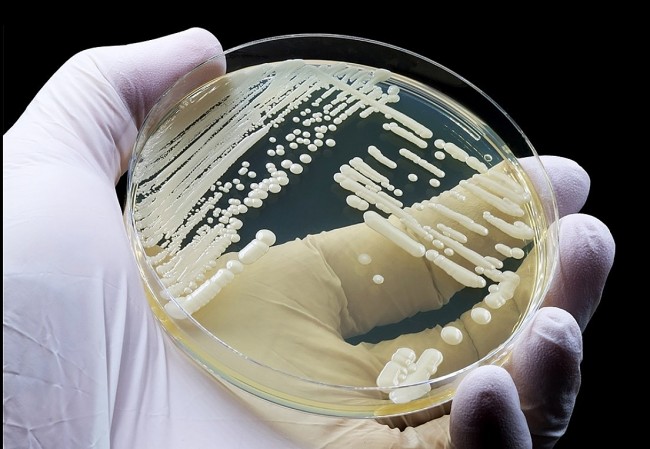
What Is Candida auris? The Drug-Resistant Superbug Now Spreading in 27 States

Candida auris, a drug-resistant fungal superbug, is spreading in hospitals across 27 U.S. states. Here’s what it is and why it’s dangerous.

Starting January 1, 2026, dozens of new U.S. laws take effect, reshaping wages, healthcare, safety rules, and digital protections nationwide.

Claims say babies get $1,000 “Trump accounts” in 2026. Here’s what the law really says — and what parents must do.

Mali and Burkina Faso barred Americans after the U.S. expanded its travel ban. Here’s why reciprocity, security vetting, and Sahel politics collided.

Discover everything coming to Disney+ in January 2026 in the U.S., including Marvel’s Wonder Man, new episodes of Percy Jackson and the Olympians Season 2, National Geographic originals, family premieres, and major movie additions. Full release schedule and quick reviews.

What are the types of veto power held by the U.S. president? A clear breakdown of regular vetoes, pocket vetoes, and their constitutional limits.

Starz reveals its January 2026 lineup featuring new Power episodes, returning dramas, and expanded franchise storytelling.

Tubi reveals its free January 2026 lineup with original movies, classic films, series, and genre highlights for the new year.

HBO Max confirms its January 2026 lineup, featuring returning series, original programming, and high-profile movie premieres.

Apple TV+ opens 2026 with major returning series, new seasons, and family favorites debuting throughout January.

Here’s the complete Acorn TV January 2026 schedule for U.S. viewers, including My Life Is Murder Season 5, Hidden Assets Season 3, and more.

Authorities found a body near the search area for missing Texas teen Camila Mendoza Olmos as investigators await official identification.

New state laws don’t stop immigration enforcement. But they do change where it happens, how agents identify themselves, and what protections immigrants have in everyday spaces like schools and hospitals.

Global icons we lost in 2025, honoring influential leaders, artists, and legends whose legacies shaped culture worldwide.

Premier League Matchweek 20 takes place January 3–4, 2026. Here’s the full U.S. schedule, kickoff times in ET, and expert takes on the games that matter most.

Premier League Matchweek 20 takes place January 3–4, 2026. Here’s the full U.S. viewing guide, with kickoff times in Eastern Time and which games stream on Peacock.

Premier League broadcast rights in 2026 are firmly locked across major markets. Here’s the verified breakdown of who owns EPL TV and streaming rights, what each deal includes, and how fans can watch.

A detailed January 2026 schedule of TV movies and one-night specials, featuring romance premieres, documentaries, comedy events, and awards-season programming.

These are the most anticipated TV shows officially confirmed for 2026, including major final seasons, high-profile returns, and long-awaited continuations.

Netflix’s early 2026 lineup is coming into focus, led by major final seasons, returning hits, and a few carefully timed new releases.